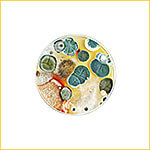
Убрать плесень в квартире казань

Сэс Казани.
Полное уничтожение
насекомых и грызунов.
✅ Работаем 24/7
✅ За 15 минут уничтожим любых вредителей
✅ Гарантия до 1 года
✅ Приедем в течение 1 часа
✅ За 15 минут уничтожим любых вредителей
✅ Гарантия до 1 года
✅ Приедем в течение 1 часа
Напишите нам Whats ap
WhatsApp
Вызов сотрудника СЭС на дом
Мы готовы анонимно приехать и оказать профессиональные услуги по дезинсекции, дератизации и обработке от плесени для любого типа помещений:
- Квартиры
- Загородные дома и дачи
- Офисы
- Рестораны, кафе и пекарни
- Магазины
- Дачные и садовые участки
Цены на услуги СЭС
Услуги по дезинсекции
Услуги по дератизации

Заключение договора частного лица с СЭС

Услуги по дезинсекции, дезинфекции и дератизации

Услуги по заключенному договору с санэпидемстанцией
Заключить договор с санэпидемстанцией может быть интересно не только юридическим лицам, но и физическому лицу, у которого в собственности есть загородный дом.

У вас остались вопросы?
Хотите оставить заявку на услуги СЭС?
Хотите оставить заявку на услуги СЭС?
Санэпидемстанция Казани «Сандез16» — СЭС: основные направления санитарной службы.
В настоящее время, как и 20 лет назад, люди встречаются с такой проблемой, как заражение квартир, комнат насекомыми-паразитами. Соответственно, встает вопрос: как избавиться от насекомых, которые не дают спокойно человеку жить. Те же 20 лет назад с такой проблемой могла помочь только государственная санэпидемстанция.
Теперь же, решить проблему с дезинсекцией от насекомых и дератизацией от грызунов помогают частные санэпидемстанции СЭС, которые появились во времена рыночной экономики и составили здоровую конкуренцию государственным специализированным службам СЭС. Санэпидемстанция «Сандез16» является частной СЭС города Казни. Для повышения качества обслуживания мы решили ограничится только территорией Татарстана.
Теперь же, решить проблему с дезинсекцией от насекомых и дератизацией от грызунов помогают частные санэпидемстанции СЭС, которые появились во времена рыночной экономики и составили здоровую конкуренцию государственным специализированным службам СЭС. Санэпидемстанция «Сандез16» является частной СЭС города Казни. Для повышения качества обслуживания мы решили ограничится только территорией Татарстана.

Если вам необходимы услуги санэпидемстанции, то логичнее всего выбор должен упасть не только на государственную СЭС, но и на частную фирму по дезинсекции. Чаще всего, добросовестные поставщики услуг дорожат своей репутацией. Изучив предложение по цене на дезинсекцию, опыт работы, отзывы клиентов, вы примете правильное решение.
Прочитав информацию на официальном сайте санэпидемстанции Казани «Сандез16», вы сами удостоверитесь в серьезном подходе СЭС к вашей проблеме.
На нашем сайте вы сможете найти адрес и телефон СЭС, позвонив по которому вы получите бесплатную консультацию нашего практикующего мастера, а также вы можете оставить заявку и мы перезвоним вам.
Прочитав информацию на официальном сайте санэпидемстанции Казани «Сандез16», вы сами удостоверитесь в серьезном подходе СЭС к вашей проблеме.
На нашем сайте вы сможете найти адрес и телефон СЭС, позвонив по которому вы получите бесплатную консультацию нашего практикующего мастера, а также вы можете оставить заявку и мы перезвоним вам.
СЭС «Сандез16» в Казани.
Фирма «Сандез16» начала свое существование в 2014 году. В штате был всего один человек и первая оказанная услуга по дезинсекции была предоставлена по ул. Блюхера города Казани. Это была обработка от клопов. Затем была практика, обучение и на сегодняшний день наши специалисты трудятся и оказывают услуги не только физическим лицам, но и коммерческим организациям.
- Наши специалисты имеют стаж не менее 5 лет
- Ежегодно участвуют в выставках и пользуются самыми современными препаратами
- Все работы проводятся с соблюдением санитарных норм и предписаний Роспотребнадзора
- Документация, которую предоставляет СЭС «Сандез16» необходима для большинства юридических лиц, для получения лицензии. Заключить договор с СЭС можно на одну или несколько видов услуг
- Услуги санэпидемстанции можно заказать по всей территории республики Татарстан
- Цены на услуги по дезинсекции, дезинфекции и дератизации существенно отличаются от конкурентов за счет большой базы клиентов
- Мы очень дорожим каждым клиентом, обратившимся в нашу службу, поэтому готовы оказать индивидуальный подход. Обратившись к нам, вы не останетесь без качественного ответа на проблему
Заключить договор по дезинсекции и дератизации в Казани.
Те клиенты, которые пожелали заключить договор с СЭС на обслуживание, получают целый ряд преимуществ, которые однозначно заинтересует любого руководителя. В договоре прописываются все услуги, которые предоставляет санитарная служба Казани «Сандез16», но воспользоваться можно любой из них по желанию заказчика.
- Продолжительность договора устанавливается по соглашению двух сторон, и может составлять от 1 дня до 12 мес
- Стоимость комплексных услуг будет значительно отличаться, как если бы эти же услуги заказывали по отдельности
- Заключив договор с «Сандез16», вы можете быть уверены, что все обязательства служба выполнит полностью и в срок
- Мы так ценим договорные отношения со своими клиентами, что готовы оказать бесплатное консультирование сверх стандартных услуг по дезинсекции от насекомых и дератизации от грызунов
Услуги СЭС Казани «Сандез16», которые вы получаете при заключении договора
Как мы писали выше, вызвать СЭС в Казани могут как юридические лица, так и частные. Для вызова вы можете воспользоваться номером телефона СЭС в шапке профиля, либо оставить свой номер и мы перезвоним вам для уточнения всех деталей и предложения наилучшего решения в вашей ситуации.
Итак, служба «Сандез16» предлагает следующий спектр услуг:
Итак, служба «Сандез16» предлагает следующий спектр услуг:
- Услуги по дезинсекции от различных видов насекомых: клопов, тараканов, муравьев и др. в квартирах, комнатах, домах, хостелах, гостиницах, ресторанах, столовых, кафе и других коммерческих помещениях
- Дератизация — борьба с грызунами: мыши, крысы. Осуществляется безопасными для человека методами и средствами.
- Акарицидная обработка участков, дач, загородных домов, баз отдыха, детских лагерей от иксодовых, боррелиозных клещей.
- Обработка от плесени стен помещений.
- Энтомологическое обследование территории (на наличие клещей на участке)
- Профилактические меры для предостережения заражения помещений от различных видов насекомых и грызунов
- Документация для юридических лиц с целью получения лицензии на определенные виды деятельности (общепит) — заключение договора с СЭС на дезинсекцию и дератизацию
Виды услуг санэпидемстанции Казани «Сандез16»
Обработка от тараканов

Обработка от мокриц

Обработка от моли

Обработка от короеда

Дезинсекция
Служба дезинсекции, дезинфекции и дератизации.
Служба санэпидемстанция Казани «Сандез16» — это высокопрофессиональная СЭС служба, которая имеет огромный опыт в борьбе насекомыми и паразитами, которые заселились в ваши квартиры, комнаты, дома или другие помещения.
Наши сотрудники имеют высокую квалификацию и огромный опыт уничтожения насекомых и грызунов. Именно поэтому, вы можете не сомневаться в том, что вам будут оказаны услуги по дезинсекции с гарантией того, что будут уничтожены такие насекомые как: тараканы, клопы, муравьи и другие.
Обработка от насекомых (дезинсекция) проводится современными препаратами, которые имеют сертификаты и разрешены для использования на территории РФ, что позволяет довольно таки успешно бороться с насекомыми грызунами в квартирах, домах, ресторанах, кафе и других коммерческих помещениях.
Наши сотрудники имеют высокую квалификацию и огромный опыт уничтожения насекомых и грызунов. Именно поэтому, вы можете не сомневаться в том, что вам будут оказаны услуги по дезинсекции с гарантией того, что будут уничтожены такие насекомые как: тараканы, клопы, муравьи и другие.
Обработка от насекомых (дезинсекция) проводится современными препаратами, которые имеют сертификаты и разрешены для использования на территории РФ, что позволяет довольно таки успешно бороться с насекомыми грызунами в квартирах, домах, ресторанах, кафе и других коммерческих помещениях.
Завелись насекомые и не знаете как избавиться от насекомых?
Дезинсекция, Дезинфекция и Дератизация по низким ценам
Звоните в службу санэпидемстанции Казани «САНДЕЗ16» — мы поможем избавиться от насекомых навсегда
Мы работаем без выходных. Мастера выезжают круглосуточно 24/7
Почему работают с нами
"Если дезинсектор отказывается жертвовать качеством во имя скорости, то именно за это его и следует вызывать."

Качественные услуги
СЭС «Сандез16» является службой по борьбе с вредителями только на территории Татарстана и имеет в своем штате профессиональных мастеров, что исключает передачу заявок некачественным исполнителям.

Опыт работы 8 лет
С 2014 года мы предоставляем услуги по дезинсекции, дезинфекции и дератизации. За это время мы выработали эффективную методику по истреблению насекомых, мышей, крыс и удаление плесени.

Гарантия результата
Мы никогда не оставим вас наедине с проблемой. Если мы беремся за ваш объект — будьте уверены, что проблема будет устранена на 100%! Это подкрепляется официальным договором.

Анонимность
Наши автомобили не имеют «опознавательных знаков», мастера не ходят в специализированных костюмах с наклейками — санэпидемстанция. Ваши соседи не догадаются, что у вас завелись клопы, тараканы или друге паразиты.
Этапы предоставления услуг СЭС "Сандез16"
1
Ваша заявка с сайта
Вы оставляете заявку здесь или звоните по номеру: +7-917-936-8088
2
Подбор лучшего решения
После уточнения деталей (вид насекомых, тип помещения), наш практикующий мастер подберет лучшее решение и цену на дезинсекцию
3
Определение даты и времени
Договариваемся об удобном для вас дне и времени, когда можем приехать к вам и предоставить услуги по дезинсекции или дератизации
4
Приезд мастера
Обработка от насекомых квартиры, комнаты, загородного дома, либо дератизация помещения.
5
Консультация
После обработки важно сделать все правильно, поэтому мы даем рекомендации, которые важно выполнить
6
Гарантийные обязательства
Выполнение всех обязательств, которые были даны после дезинсекции, дезинфекции и дератизации объекта
Оставьте ваши данные
Наш лучший мастер перезвонит вам в рабочее время
Нажимая кнопку «Отправить», вы соглашаетесь
с условиями политики конфиденциальности
с условиями политики конфиденциальности

Дезинсекция
Обработка от короеда
Обработка от мокриц
Дератизация
Уничтожение крыс
Уничтожение мышей
Уничтожение кротов
Дезинфекция

Работаем круглосуточно

Работаем по Казани и Татарстану